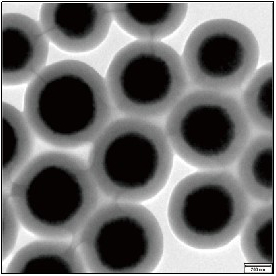
新闻图片3

9 年
手机商铺
公司新闻/正文
3864 人阅读发布时间:2021-02-26 11:15
核酸提取传统方法
传统的提取方法主要有:酚抽提法、醇沉淀、亲和层析柱、密度梯度离心和硅胶柱法。这些传统提取方法可从不同组织样本中分离出DNA和RNA,但这些技术中包含沉淀和离心等操作步骤,其所需的生物样本量较大,提取步骤较为繁杂、费时费力,得率也不高,难以实现自动化操作,另外,大部分的传统方法中还需要用到有毒化学试剂,对操作人员的健康具有潜在危害,因此,伴随着分子生物学以及材料学的发展,采用磁珠的方法从液相系统中分离纯化核酸的新方法已经崛起。
磁珠法分离核酸的原理
纳米磁珠是高分子材料或者生物分子包被四氧化三铁核心而形成的,可以被磁铁吸附的同时纳米小球。用于核酸纯化的磁珠表面功能基团一般为(OH)和羧基(COOH)。

磁珠分离核酸核心技术是固相可逆固定化技术,但磁珠和核酸具体是如果相互作用吸附在一起,目前还不是很清楚,盐桥理论是其中猜想之一。在利用磁珠结合核酸的体系中,由于缓冲液的作用核酸分子(DNA & RNA)会由线性变成球状,暴露出核酸骨架上大量的负电基团与反应体系中的阳离子连接,在磁珠外层负电基团的作用下,形成“阴离子-阳离子-阴离子”的盐桥结构,使核酸分子被特异性地吸附到磁珠表面。而当反应缓冲液被弃除后,加入水性分子,会快速充分水化核酸分子,解除三者之间的离子相互作用,使吸附到磁珠上的核酸分子被纯化出来。
海狸核酸提取磁珠

磁珠法核酸提取是纳米科技与生物技术的完美结合。纳米磁珠由于尺寸小,具有超大的比表面积。利用纳米技术对磁珠表面进行修饰,使磁珠表面具有更多核酸结合位点,从提高了纳米磁珠对核酸提取回收效率和灵敏度。
海狸核酸提取具有如下特点:
1. 磁珠生产工艺控制严格。每颗磁珠都呈现规整的球形,以保证低丰度样本提取的稳定性。
2. 磁珠表面特殊化处理,可实现DNA/RNA共提取。
3. 同样适合低丰度样本,包括游离DNA,病毒DNA和RNA。
4. 产能稳定,月产能可达10kg。
5. 批次稳定,不同批次核酸提取效率CV<10%。
6. 可实现高通量和自动化操作,配合核酸提取仪最快可实现9min提取。
最低可提取100拷贝/mL病毒的RNA
2020年12月30日,国家卫健委发布的《医疗机构新冠病毒核酸检测工作手册(试行第二版)》中在性能验证一项明确要求“在用于临床标本检测前,实验室应对由提取试剂、提取仪、扩增试剂、扩增仪等组成检测系统进行必要的性能验证,性能指标包括但不限于精密度(至少要有重复性)和最低检测限。建议选用高灵敏的试剂(检测限≤500拷贝/ml)。”国内新冠病毒检测试剂盒的灵敏度大部分布在200-1000拷贝/mL之间。核酸提取的灵敏度是病毒检测试剂盒灵敏度的关键,提高核酸提取试剂盒的灵敏度高可以大大提高病毒检测的准确性。
表1:采用海狸磁珠进行新冠假病毒保存液(病毒浓度为100拷贝/mL)核酸提取的检测数据。
| 品牌 |
BEAVER |
对照 |
| Ct |
34.81 |
35.47 |

取200μL新冠假病毒保存液(病毒浓度为100拷贝/mL),利用海狸磁珠进行病毒核酸提取,RT-qPCR检测获得核酸的浓度,其Ct值为34.81,比竞品提前0.66。即,海狸磁珠可提取低至20个拷贝的病毒核酸。
相关产品
| 英文名称 |
中文名称 |
货号 |
型号 |
| BeaverBeads Mag OH-500 |
二氧化硅羟基磁珠500nm |
70301 |
10 mg/mL,500 nm |
| BeaverBeads Mag OH-1000 |
二氧化硅羟基磁珠1μm |
70302 |
10 mg/mL,1000 nm |
| BeaverBeads Mag COOH-S500 |
二氧化硅羧基磁珠S500 |
70107 |
510 mg/mL,500nm |
| BeaverBeads Mag COOH-NS500 |
二氧化硅羧基磁珠NS500 |
70108 |
10 mg/mL,500nm |
| BeaverBeads™ Mag COOH-PC300 |
二氧化硅羧基磁珠(300nm) |
70111 |
50mg/mL,300nm |
| BeaverBeads™ Mag COOH-SC300 |
二氧化硅羧基磁珠(300nm) |
70112 |
50mg/mL,300nm |
| BeaverBeads Mag COOH |
羧基磁珠(300nm) |
70106 |
10 mg/mL,300 nm |